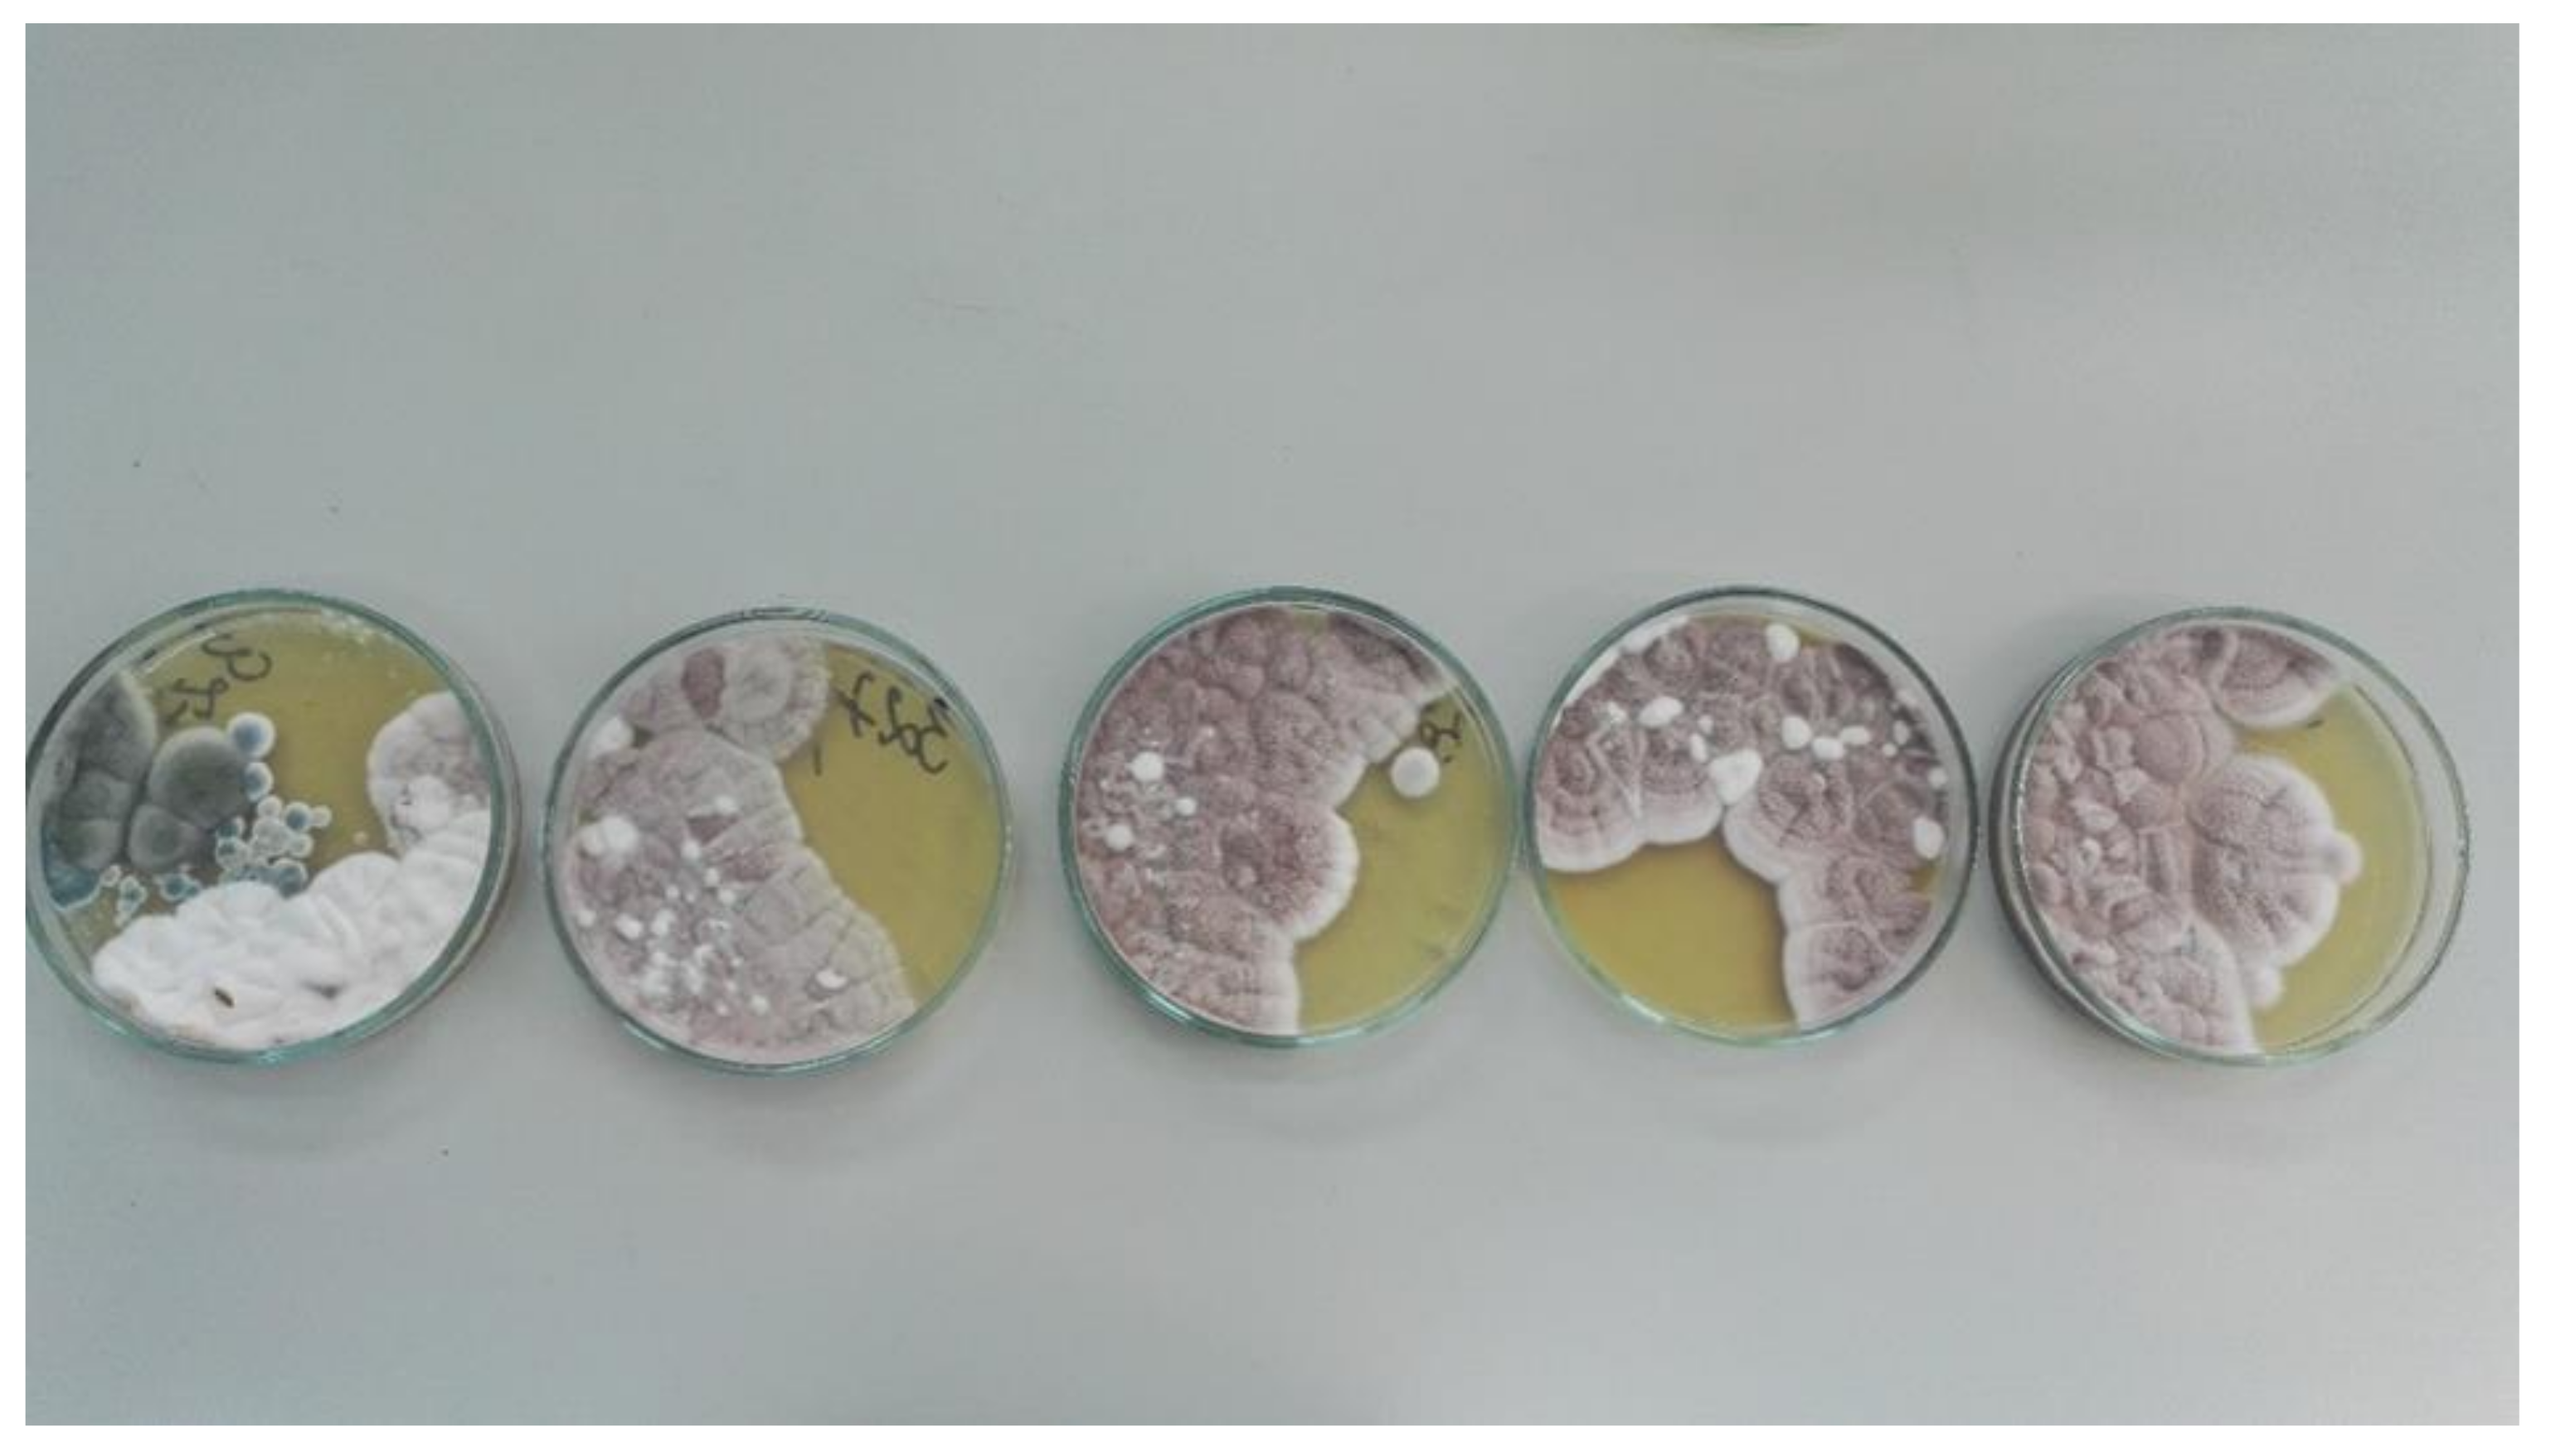

Microbiological Evaluation of Water Used in Dental Units
Abstract
1. Introduction
2. Materials and Methods
2.1. Sample Collection
2.2. Analysis
3. Results
4. Discussion
4.1. International Dental Water Guidelines and Our Research Result
4.2. Comparison to the Results of Research by Other Authors
4.3. Methods for Improving the Quality of Dental Water
5. Conclusions
Supplementary Materials
Author Contributions
Funding
Institutional Review Board Statement
Informed Consent Statement
Data Availability Statement
Acknowledgments
Conflicts of Interest
References
- Wynbrandt, J. The Excruciating History of Dentistry. Sciences 1998, 38, 45. [Google Scholar]
- Jańczuk, Z. Podręcznik Dla Asystentek i Higienistek Stomatologicznych; Wydawnictwo Lekarskie PZWL: Warszawa, Poland, 1994. [Google Scholar]
- Dziennik Ustaw Rzeczypospolitej Polskiej. In Rozporządzenie Ministra Zdrowia z Dnia 7 Grudnia 2017 r. w Sprawie Jakości Wody Przeznaczonej do Spożycia Przez Ludzi; Ministerstwo Zdrowia: Warszawa, Poland, 2017.
- Szymanska, J. Biofilm and Dental Unit Waterlines. Ann. Agric. Environ. Med. 2003, 10, 151–157. [Google Scholar]
- Barbeau, J.; Tanguay, R.; Faucher, E.; Avezard, C.; Trudel, L.; Côté, L.; Prévost, A.P. Multiparametric Analysis of Waterline Contamination in Dental Units. Appl. Environ. Microbiol. 1996, 62, 3954–3959. [Google Scholar] [CrossRef]
- Challacombe, S.J.; Fernandes, L.L. Detecting Legionella Pneumophila in Water Systems: A Comparison of Various Dental Units. J. Am. Dent. Assoc. 1995, 126, 603–608. [Google Scholar] [CrossRef]
- Al-Hiyasat, A.S.; Ma’ayeh, S.Y.; Hindiyeh, M.Y.; Khader, Y.S. The Presence of Pseudomonas Aeruginosa in the Dental Unit Waterline Systems of Teaching Clinics. Int. J. Dent. Hyg. 2007, 5, 36–44. [Google Scholar] [CrossRef]
- Szymanska, J. Bacterial Contamination of Water in Dental Unit Reservoirs. Ann. Agric. Environ. Med. 2007, 14, 137–140. [Google Scholar]
- Williams, H.N.; Baer, M.L.; Kelley, J.I. Contribution of Biofilm Bacteria to the Contamination of the Dental Unit Water Supply. J. Am. Dent. Assoc. 1995, 126, 1255–1260. [Google Scholar] [CrossRef]
- Kołwzan, B. Analiza Zjawiska Biofilmu–Warunki Jego Powstawania i Funkcjonowania. Ochr. Środowiska 2011, 33, 3–14. [Google Scholar]
- Pankhurst, C.L.; Johnson, N.W.; Woods, R.G. Microbial Contamination of Dental Unit Waterlines: The Scientific Argument. Int. Dent. J. 1998, 48, 359–368. [Google Scholar] [CrossRef]
- Shepherd, P.A.; Shojaei, M.A.; Eleazer, P.; Stewart, A.; Staat, R. Clearance of Biofilms from Dental Unit Waterlines through the Use of Hydroperoxide Ion-Phase Transfer Catalysts. Quintessence Int. 2000, 32, 755–761. [Google Scholar]
- Tall, B.D.; Williams, H.N.; George, K.S.; Gray, R.T.; Walch, M. Bacterial Succession within a Biofilm in Water Supply Lines of Dental Air-Water Syringes. Can. J. Microbiol. 1995, 41, 647–654. [Google Scholar] [CrossRef] [PubMed]
- Walker, J.T.; Bradshaw, D.J.; Bennett, A.M.; Fulford, M.R.; Martin, M.V.; Marsh, P.D. Microbial Biofilm Formation and Contamination of Dental-Unit Water Systems in General Dental Practice. Appl. Environ. Microbiol. 2000, 66, 3363–3367. [Google Scholar] [CrossRef] [PubMed]
- Bzdęga, W.; Trykowski, J.; Bzdęga, J. The disinfection of water and compressed air systems of a dental unit 1. Now. Lek. 2007, 76, 436–439. [Google Scholar]
- Balcerzak, Ł. Biofilm w Przewodach Wodnych Unitów Stomatologicznych i Skuteczna Walka z Nim–Forum Stomatologii Praktycznej. Available online: https://www.praktycznastomatologia.pl/artykul/biofilm-w-przewodach-wodnych-unitow-stomatologicznych-i-skuteczna-walka-z-nim (accessed on 7 January 2022).
- Ricci, M.L.; Fontana, S.; Pinci, F.; Fiumana, E.; Pedna, M.F.; Farolfi, P.; Sabattini, M.A.B.; Scaturro, M. Pneumonia Associated with a Dental Unit Waterline. Lancet 2012, 379, 684. [Google Scholar] [CrossRef]
- Atlas, R.M.; Williams, J.F.; Huntington, M.K. Legionella Contamination of Dental-Unit Waters. Appl. Environ. Microbiol. 1995, 61, 1208–1213. [Google Scholar] [CrossRef] [PubMed]
- Barbeau, J. Waterborne Biofilms and Dentistry: The Changing Face of Infection Control. J. Can. Dent. Assoc. 2000, 66, 539–541. [Google Scholar]
- Szymanska, J. Dental Bioaerosol as an Occupational Hazard in a Dentist’s Workplace. Ann. Agric. Environ. Med. 2007, 14, 203-7. [Google Scholar]
- Kimmerle, H.; Wiedmann-Al-Ahmad, M.; Pelz, K.; Wittmer, A.; Hellwig, E.; Al-Ahmad, A. Airborne Microbes in Different Dental Environments in Comparison to a Public Area. Arch. Oral Biol. 2012, 57, 689–696. [Google Scholar] [CrossRef]
- Mills, S.E. The Dental Unit Waterline Controversy: Defusing the Myths, Defining the Solutions. J. Am. Dent. Assoc. 2000, 131, 1427–1441. [Google Scholar] [CrossRef]
- Vielkind, P.; Jentsch, H.; Eschrich, K.; Rodloff, A.C.; Stingu, C.S. Prevalence of Actinomyces spp. in Patients with Chronic Periodontitis. Int. J. Med. Microbiol. 2015, 305, 682–688. [Google Scholar] [CrossRef]
- Althaf, M.M.; Abdelsalam, M.S.; Alsunaid, M.S.; Hussein, M.H. Brevibacterium Casei Isolated as a Cause of Relapsing Peritonitis. BMJ Case Rep. 2014, 2014, bcr2014203611. [Google Scholar] [CrossRef] [PubMed]
- Corvec, S. Clinical and Biological Features of Cutibacterium (Formerly Propionibacterium) Avidum, an Underrecognized Microorganism. Clin. Microbiol. Rev. 2018, 31, e00064-17. [Google Scholar] [CrossRef] [PubMed]
- Maurer, S.M.; Kursawe, L.; Rahm, S.; Prinz, J.; Zinkernagel, A.S.; Moter, A.; Kuster, S.P.; Zbinden, R.; Zingg, P.O.; Achermann, Y. Cutibacterium Avidum Resists Surgical Skin Antisepsis in the Groin-a Potential Risk Factor for Periprosthetic Joint Infection: A Quality Control Study. Antimicrob. Resist. Infect. Control 2021, 10, 27. [Google Scholar] [CrossRef] [PubMed]
- Almagro-Molto, M.; Suerbaum, S.; Schubert, S. Ulcerative Keratitis Due to Kocuria Palustris: An Emerging Pathogen. Enfermedades Infecc. Y Microbiol. Clin. 2019, 37, 422–423. [Google Scholar] [CrossRef] [PubMed]
- Bernshteyn, M.; Kumar, P.A.; Joshi, S. Kocuria Kristinae Pneumonia and Bacteremia. Proc. Bayl. Univ. Med. Cent. 2020, 33, 608–609. [Google Scholar] [CrossRef] [PubMed]
- Dempsey, K.E.; Riggio, M.P.; Lennon, A.; Hannah, V.E.; Ramage, G.; Allan, D.; Bagg, J. Identification of Bacteria on the Surface of Clinically Infected and Non-Infected Prosthetic Hip Joints Removed during Revision Arthroplasties by 16S RRNA Gene Sequencing and by Microbiological Culture. Arthritis Res. Ther. 2007, 9, R46. [Google Scholar] [CrossRef]
- Gneiding, K.; Frodl, R.; Funke, G. Identities of Microbacterium Spp. Encountered in Human Clinical Specimens. J. Clin. Microbiol. 2008, 46, 3646–3652. [Google Scholar] [CrossRef]
- Szewczyk, E.M. Diagnostyka Bakteriologiczna, 2nd ed.; PWN: Warszawa, Poland, 2013. [Google Scholar]
- Chiu, C.H.; Lee, Y.T.; Wang, Y.C.; Yin, T.; Kuo, S.C.; Yang, Y.S.; Chen, T.L.; Lin, J.C.; Wang, F.D.; Fung, C.P. A Retrospective Study of the Incidence, Clinical Characteristics, Identification, and Antimicrobial Susceptibility of Bacteremic Isolates of Acinetobacter Ursingii. BMC Infect. Dis. 2015, 15, 400. [Google Scholar] [CrossRef]
- Wong, D.; Nielsen, T.B.; Bonomo, R.A.; Pantapalangkoor, P.; Luna, B.; Spellberg, B. Clinical and Pathophysiological Overview of Acinetobacter Infections: A Century of Challenges. Clin. Microbiol. Rev. 2017, 30, 409–447. [Google Scholar] [CrossRef]
- Mohanty, A.; Kabi, A.; Mohanty, A. Acinetobacter Lwoffii–Emerging Pathogen Causing Liver Abscess: A Case Report. Natl. J. Integr. Res. Med. 2018, 9, 53–54. [Google Scholar]
- Grün, A.Y.; Meier, J.; Metreveli, G.; Schaumann, G.E.; Manz, W. Sublethal Concentrations of Silver Nanoparticles Affect the Mechanical Stability of Biofilms. Environ. Sci. Pollut. Res. Int. 2016, 23, 24277–24288. [Google Scholar] [CrossRef] [PubMed]
- Yekani, M.; Baghi, H.B.; Naghili, B.; Vahed, S.Z.; Sóki, J.; Memar, M.Y. To Resist and Persist: Important Factors in the Pathogenesis of Bacteroides Fragilis. Microb. Pathog. 2020, 149, 104506. [Google Scholar] [CrossRef] [PubMed]
- Jacobs, J.L.; Fasi, A.C.; Ramette, A.; Smith, J.J.; Hammerschmidt, R.; Sundin, G.W. Identification and Onion Pathogenicity of Burkholderia Cepacia Complex Isolates from the Onion Rhizosphere and Onion Field Soil. Appl. Environ. Microbiol. 2008, 74, 3121–3129. [Google Scholar] [CrossRef] [PubMed]
- D’Inzeo, T.; Santangelo, R.; Fiori, B.; De Angelis, G.; Conte, V.; Giaquinto, A.; Palucci, I.; Scoppettuolo, G.; Di Florio, V.; Giani, T.; et al. Catheter-Related Bacteremia by Cupriavidus Metallidurans. Diagn. Microbiol. Infect. Dis. 2015, 81, 9–12. [Google Scholar] [CrossRef]
- Kaper, J.B. Pathogenic Escherichia Coli. Int. J. Med. Microbiol. 2005, 295, 355–356. [Google Scholar] [CrossRef]
- Liu, H.; Zhu, J.; Hu, Q.; Rao, X. Morganella Morganii, a Non-Negligent Opportunistic Pathogen. Int. J. Infect. Dis. 2016, 50, 10–17. [Google Scholar] [CrossRef]
- Kumar, R.; Verma, H.; Haider, S.; Bajaj, A.; Sood, U.; Ponnusamy, K.; Nagar, S.; Shakarad, M.N.; Negi, R.K.; Singh, Y.; et al. Comparative Genomic Analysis Reveals Habitat-Specific Genes and Regulatory Hubs within the Genus Novosphingobium. mSystems 2017, 2, e00020-17. [Google Scholar] [CrossRef]
- Fernandez, S.G.M. Five Cases of Pantoea Septica Related Catheter Infections. In Proceedings of the Abstract E0270, Presented 28th ECCMID, Madrid, Spain, 21–24 April 2018. [Google Scholar]
- Loong, S.K.; Tan, K.K.; Zulkifle, N.I.; AbuBakar, S. Draft Genome of Paraburkholderia Fungorum Sequence Type 868 Recovered from Human Synovial Tissues. Data Brief 2019, 25, 104159. [Google Scholar] [CrossRef]
- Fernández, M.; Porcel, M.; de la Torre, J.; Molina-Henares, M.A.; Daddaoua, A.; Llamas, M.A.; Roca, A.; Carriel, V.; Garzón, I.; Ramos, J.L.; et al. Analysis of the Pathogenic Potential of Nosocomial Pseudomonas Putida Strains. Front. Microbiol. 2015, 6, 871. [Google Scholar] [CrossRef]
- Bedir Demirdag, T.; Ozkaya-Parlakay, A.; Bayrakdar, F.; Gulhan, B.; Kanik Yuksek, S.; Suzuk Yildiz, S.; Mumcuoglu, İ.; Dinc, B.; Yarali, N. An Outbreak of Ralstonia Pickettii Bloodstream Infection among Pediatric Leukemia Patients. J. Microbiol. Immunol. Infect. 2021, 55, 80–85. [Google Scholar] [CrossRef]
- Pandey, R.; Barman, P.; Sengupta, S. Ralstonia Pickettii Bacteremia. J. Infect. Dis. Ther. 2014, 2. [Google Scholar] [CrossRef]
- Strateva, T.; Kostyanev, T.; Setchanova, L. Ralstonia Pickettii Sepsis in a Hemodialysis Patient from Bulgaria. Braz. J. Infect. Dis. 2012, 16, 400–401. [Google Scholar] [CrossRef] [PubMed][Green Version]
- Batra, P.; Mathur, P.; Misra, M.C. Clinical Characteristics and Prognostic Factors of Patients with Stenotrophomonas Maltophilia Infections. J. Lab. Physicians 2017, 9, 132–135. [Google Scholar] [CrossRef] [PubMed]
- Dzierżanowska, D. Zakażenia Szpitalne, 2nd ed.; Alfa Medica Press: Bielsko-Biała, Poland, 2008. [Google Scholar]
- Asmah, N. Pathogenicity Biofilm Formation of Enterococcus Faecalis. J. Syiah Kuala Dent. Soc. 2020, 5, 47–50. [Google Scholar] [CrossRef]
- Fernández-Hidalgo, N.; Escolà-Vergé, L. Enterococcus Faecalis Bacteremia: Consider an Echocardiography, But Consult an Infectious Diseases Specialist. J. Am. Coll. Cardiol. 2019, 74, 202–204. [Google Scholar] [CrossRef]
- Martín Guerra, J.M.; Martín Asenjo, M.; Rodríguez Martín, C. Bacteraemia by Micrococcus Luteus in an Inmunocompromised Patient. Med. Clin. 2019, 152, 469–470. [Google Scholar] [CrossRef]
- Shahandeh, Z.; Shafi, H.; Sadighian, F. Association of Staphylococcus Cohnii Subspecies Urealyticum Infection with Recurrence of Renal Staghorn Stone. Casp. J. Intern. Med. 2015, 6, 40. [Google Scholar]
- Soldera, J.; Nedel, W.L.; Cardoso, P.R.C.; d’Azevedo, P.A. Bacteremia Due to Staphylococcus cohnii ssp. Urealyticus Caused by Infected Pressure Ulcer: Case Report and Review of the Literature. Sao Paulo Med. J. 2013, 131, 59–61. [Google Scholar] [CrossRef]
- Motta, J.C.; Forero-Carreño, C.; Arango, Á.; Sánchez, M. Staphylococcus Cohnii Endocarditis in Native Valve. New Microbes New Infect. 2020, 38, 100825. [Google Scholar] [CrossRef]
- Szczuka, E.; Krajewska, M.; Lijewska, D.; Bosacka, K.; Kaznowski, A. Diversity of Staphylococcal Cassette Chromosome Mec Elements in Nosocomial Multiresistant Staphylococcus Haemolyticus Isolates. J. Appl. Genet. 2016, 57, 543–547. [Google Scholar] [CrossRef][Green Version]
- Brooks, D.; Thomas, V.; Snowden, J. Staphylococcus Capitis Osteomyelitis: Case Report. Glob. Pediatr. Health 2019, 6, 2333794X19833736. [Google Scholar] [CrossRef] [PubMed]
- Burkholder, K.M.; O’Riordan, M.X.D. Opportunisitic Pathogens of Humans. In The Rasputin Effect: When Commensals and Symbionts Become Parasitic; Springer: Berlin/Heidelberg, Germany, 2016; pp. 301–357. [Google Scholar]
- Jiang, S.; Zheng, B.; Ding, W.; Lv, L.; Ji, J.; Zhang, H.; Xiao, Y.; Li, L. Whole-Genome Sequence of Staphylococcus Hominis, an Opportunistic Pathogen. J. Bacteriol. 2012, 194, 4761–4762. [Google Scholar] [CrossRef] [PubMed]
- Savini, V.; Catavitello, C.; Carlino, D.; Bianco, A.; Pompilio, A.; Balbinot, A.; Piccolomini, R.; Di Bonaventura, G.; D’Antonio, D. Staphylococcus Pasteuri Bacteraemia in a Patient with Leukaemia. J. Clin. Pathol. 2009, 62, 957–958. [Google Scholar] [CrossRef] [PubMed]
- Ramnarain, J.; Yoon, J.; Runnegar, N. Staphylococcus Pasteuri Infective Endocarditis: A Case Report. IDCases 2019, 18, e00656. [Google Scholar] [CrossRef]
- Santoiemma, P.P.; Kalainov, D.M.; Mehta, M.P.; Bolon, M.K. An Unusual Case of Staphylococcus Pasteuri Osteomyelitis. Infect. Dis. Rep. 2020, 12, 32–34. [Google Scholar] [CrossRef]
- Yendo, T.M.; Valente, N.S.; Nico, M.M.S. Botryomycosis Caused by Staphylococcus Warneri: The First Case Reported. Int. J. Dermatol. 2021, 60, 509–511. [Google Scholar] [CrossRef]
- Arslan, F.; Saltoglu, N.; Mete, B.; Mert, A. Recurrent Staphylococcus Warnerii Prosthetic Valve Endocarditis: A Case Report and Review. Ann. Clin. Microbiol. Antimicrob. 2011, 10, 14. [Google Scholar] [CrossRef]
- Brand, Y.E.; Rufer, B. Late Prosthetic Knee Joint Infection with Staphylococcus Xylosus. IDCases 2021, 24. [Google Scholar] [CrossRef]
- Sadjadi, S.A.; Ali, H. Streptococcus Parasanguis Peritonitis: Report of a Case and Review of the Literature. Perit. Dial. Int. 2011, 31, 603–604. [Google Scholar] [CrossRef]
- Cardoso, J.; Ferreira, D.; Assis, R.; Monteiro, J.; Coelho, I.; Real, A.; Catorze, N. Streptococcus Oralis Meningitis. Eur. J. Case Rep. Intern. Med. 2021, 8, 133–134. [Google Scholar] [CrossRef]
- Mehanna, C.J.; Kallassi, L.; Mansour, A.M.; Hamam, R.N. Streptococcus Salivarius Endogenous Endophthalmitis. BMJ Case Rep. 2021, 14, e239299. [Google Scholar] [CrossRef] [PubMed]
- Shivamurthy, V.M.; Gantt, S.; Reilly, C.; Tilley, P.; Guzman, J.; Tucker, L. Bacillus Pumilus Septic Arthritis in a Healthy Child. Can. J. Infect. Dis. Med. Microbiol. J. Can. Mal. Infect. Microbiol. Med. 2016, 2016, 3265037. [Google Scholar] [CrossRef][Green Version]
- Tena, D.; Martinez-Torres, J.A.; Perez-Pomata, M.T.; Sáez-Nieto, J.A.; Rubio, V.; Bisquert, J. Cutaneous Infection Due to Bacillus Pumilus: Report of 3 Cases. Clin. Infect. Dis. 2007, 44, e40–e42. [Google Scholar] [CrossRef] [PubMed]
- Bennaoui, F.; El, N.; Slitine, I.; Rabii, K.; Soraa, N.; Maoulainine, F. Bacillus Pumilus Septicemia: A Neonatal Case. Int. J. Res. Stud. Med. Heal Sci. 2021, 6, 18–20. [Google Scholar] [CrossRef]
- Heidt, J.; Papaloukas, N.; Timmerman, C.P. A rare bloodstream infection: Bacillus mycoides. Neth. J. Med. 2019, 77, 227–230. [Google Scholar] [PubMed]
- Soufiane, B.; Côté, J.C. Bacillus Weihenstephanensis Characteristics Are Present in Bacillus Cereus and Bacillus Mycoides Strains. FEMS Microbiol. Lett. 2013, 341, 127–137. [Google Scholar] [CrossRef]
- Crisafulli, E.; Aredano, I.; Valzano, I.; Burgazzi, B.; Andrani, F.; Chetta, A. Pleuritis with Pleural Effusion Due to a Bacillus Megaterium Infection. Respirol. Case Rep. 2018, 7, e00381. [Google Scholar] [CrossRef]
- Aronoff, D.M.; Kazanjian, P.H. Historical and Contemporary Features of Infections Due to Clostridium Novyi. Anaerobe 2018, 50, 80–84. [Google Scholar] [CrossRef]
- Watanabe, N.; Kobayashi, K.; Hashikita, G.; Taji, Y.; Ishibashi, N.; Sakuramoto, S.; Mitsutake, K.; Ikebuchi, K.; Ebihara, Y. Hepatic Gas Gangrene Caused by Clostridium Novyi. Anaerobe 2019, 57, 90–92. [Google Scholar] [CrossRef]
- Nikolaitchouk, N.; Wacher, C.; Falsen, E.; Andersch, B.; Collins, M.D.; Lawson, P.A. Lactobacillus Coleohominis Sp. Nov., Isolated from Human Sources. Int. J. Syst. Evol. Microbiol. 2001, 51, 2081–2085. [Google Scholar] [CrossRef]
- Doi, A.; Nakajo, K.; Kamiya, T.; Ohkusu, K. Splenic Abscess Caused by Lactobacillus Paracasei. J. Infect. Chemother. 2011, 17, 122–125. [Google Scholar] [CrossRef] [PubMed]
- Ryan, M.P.; Pembroke, J.T. Brevundimonas spp.: Emerging Global Opportunistic Pathogens. Virulence 2018, 9, 480–493. [Google Scholar] [CrossRef] [PubMed]
- Göker, T.; Aşık, R.Z.; Yılmaz, M.B.; Çelik, İ.; Tekiner, A. Sphingomonas Paucimobilis: A Rare Infectious Agent Found in Cerebrospinal Fluid. J. Korean Neurosurg. Soc. 2017, 60, 481–483. [Google Scholar] [CrossRef]
- Ryan, M.P.; Adely, C.; Butt, A. Sphingomonas Paucimobilis. Available online: https://www.researchgate.net/publication/287632829_Sphingomonas_paucimobilis (accessed on 8 January 2022).
- Zhang, Y.; Yang, H.; Turra, D.; Zhou, S.; Ayhan, D.H.; DeIulio, G.A.; Guo, L.; Broz, K.; Wiederhold, N.; Coleman, J.J.; et al. The Genome of Opportunistic Fungal Pathogen Fusarium Oxysporum Carries a Unique Set of Lineage-Specific Chromosomes. Commun. Biol. 2020, 3, 50. [Google Scholar] [CrossRef] [PubMed]
- Murray, P.R.; Rosenthal, K.S.; Pfaller, M.A. Medical Microbiology E-Book; Elsevier Health Sciences: Amsterdam, The Netherlands, 2020. [Google Scholar]
- Krzyściak, P.; Skóra, M. Grzyby Jako Czynniki Etiologiczne Wybranych Zakażeń Szpitalnych. Zakażenia XXI Wieku 2019, 2, 139–149. [Google Scholar] [CrossRef]
- Krzyściak, P.; Macura, A.B.; Skóra, M. Atlas Grzybów Chorobotwórczych Człowieka; MedPharm: Wrocław, Poland, 2011. [Google Scholar]
- Szymańska, J.; Sitkowska, J. Bacterial Contamination of Dental Unit Waterlines. Environ. Monit. Assess. 2013, 185, 3603–3611. [Google Scholar] [CrossRef] [PubMed]
- Uzel, A.; Cogulu, D.; Oncag, O. Microbiological Evaluation and Antibiotic Susceptibility of Dental Unit Water Systems in General Dental Practice. Int. J. Dent. Hyg. 2008, 6, 43–47. [Google Scholar] [CrossRef]
- Szymańska, J.; Sitkowska, J. Opportunistic Bacteria in Dental Unit Waterlines: Assessment and Characteristics. Future Microbiol. 2013, 8, 681–689. [Google Scholar] [CrossRef]
- Arvand, M.; Hack, A. Microbial Contamination of Dental Unit Waterlines in Dental Practices in Hesse, Germany: A Cross-Sectional Study. Eur. J. Microbiol. Immunol. 2013, 3, 49–52. [Google Scholar] [CrossRef]
- Gawish, S.; Abbass, A.; Abaza, A. Occurrence and Biofilm Forming Ability of Pseudomonas Aeruginosa in the Water Output of Dental Unit Waterlines in a Dental Center in Alexandria, Egypt. Germs 2019, 9, 71–80. [Google Scholar] [CrossRef]
- de Souza-Gugelmin, M.C.M.; Lima, C.D.T.; de Lima, S.N.M.; Mian, H.; Ito, I.Y. Microbial Contamination in Dental Unit Waterlines. Braz. Dent. J. 2003, 14, 55–57. [Google Scholar] [CrossRef] [PubMed][Green Version]
- Mazari, W.; Boucherit-Otmani, Z.; El Haci, I.A.; Ilahi, A.; Boucherit, K. Risk Assessment for the Spread of Candida Sp. in Dental Chair Unit Waterlines Using Molecular Techniques. Int. Dent. J. 2018, 68, 386–392. [Google Scholar] [CrossRef] [PubMed]
- Lisboa, G.M.; Lisboa, Y.R.M.; Pinheiro, T.M.L.; Stegun, R.C.; da Silva-Filho, E.A. Microbial Diversity in Dental Unit Waterlines. Acta Odontol. Latinoam. 2014, 27, 110–114. [Google Scholar] [CrossRef] [PubMed]
- Damasceno, J.L.; Santos, R.A.D.; Barbosa, A.H.; Casemiro, L.A.; Pires, R.H.; Martins, C.H.G. Risk of Fungal Infection to Dental Patients. Sci. World J. 2017, 2017, 2982478. [Google Scholar] [CrossRef]
- Rickard, G.D.; Richardson, R.J.; Johnson, T.M.; McColl, D.C.; Hooper, L. Ozone Therapy for the Treatment of Dental Caries. Cochrane Database Syst. Rev. 2004, 3. [Google Scholar] [CrossRef]
- Odonnell, M.J.; Boyle, M.A.; Russell, R.J.; Coleman, D.C. Management of Dental Unit Waterline Biofilms in the 21st Century. Future Microbiol. 2011, 6, 1209–1226. [Google Scholar] [CrossRef]
- Spagnolo, A.M.; Sartini, M.; Cristina, M.L. Microbial Contamination of Dental Unit Waterlines and Potential Risk of Infection: A Narrative Review. Pathogens 2020, 9, 651. [Google Scholar] [CrossRef]

| Microorganisms | Presence in Dental Units | Proportion [%] | Pathogenicity |
|---|---|---|---|
| Gram-positive bacteria | |||
| A. dentalis | 1 | 2.9 | periodontitis [23] |
| A. oris | 1 | 2.9 | oral microbiota [23] |
| B. casei | 2 | 5.9 | opportunistic pathogen that causes peritonitis in immunocompromised patients [24] |
| B. celere | 1 | 2.9 | no literature data available |
| C. avidum | 1 | 2.9 | opportunistic pathogen that is present primarily in immunocompromised patients receiving chemotherapy and radiotherapy (cutaneous abscesses, infective endocarditis), deep tissue infections [25]; potential aetiological agent of periprosthetic joint infection [26] |
| K. palustris | 3 | 8.8 | bacteraemia, endocarditis, peritonitis, cholecystitis, urinary tract infections, brain abscesses, and keratitis [27] |
| K. kristinae | 1 | 2.9 | bacteraemia associated with the use of central venous catheter, infective endocarditis, acute peritonitis, abdominal abscesses, umbilical sepsis, acute cholecystitis, and urinary tract infection [28] |
| L. shinshuensis | 13 | 38.2 | Combined with other bacterial species, they cause infections associated with the use of central venous catheters used as vascular access to haemodialysis [29]. |
| M. phyllosphaerae | 2 | 5.9 | plant pathogen; a case of prosthetic hip infection has been described [30] |
| M. ginsengisoli | 5 | 14.7 | no literature data available |
| M. testaceum | 3 | 8.8 | blood poisonings, urinary tract infections [30] |
| M. esteraromaticum | 2 | 5.9 | blood poisonings [30] |
| R. dentocariosa | 1 | 2.9 | caries, infections of paradental tissues and opportunistic infections: endocarditis, peritonitis, sepsis, lung abscesses, pneumonia in patients with immune deficiencies, neoplasms [31] |
| R. amarae | 4 | 11.76 | bloodstream infections in haematological patients with comorbidities [31] |
| Gram-negative bacteria | |||
| A. ursingii | 3 | 8.8 | bacteraemia in patients with haematological neoplasms and neutropenia [32] |
| A. lwoffii | 1 | 2.9 | microbiota of the oropharynx, skin, and perineum in approx. 25% of healthy individuals; opportunistic pathogen in immunocompromised patients and nosocomial infections: sepsis, pneumonia, meningitis, and wound infections [33,34] |
| A. citratiphilum | 1 | 2.9 | occurs in water systems [35]; no reports concerning pathogenicity |
| B. fragilis | 1 | 2.9 | peritonitis; soft tissue infections; pelvic, lung, and brain abscesses [36] |
| B. cepacia | 9 | 26.47 | opportunistic pathogen in patients with cystic fibrosis [37], involved in nosocomial infections |
| B. pyrrocinia | 1 | 2.9 | no literature data available |
| C. metallidurans | 8 | 25.53 | catheter-related infections [38] |
| C. pauculus | 2 | 5.9 | bacteraemia in haematological, oncologic, and diabetic patients and those with chronic heart failure [38] |
| E. coli | 1 | 2.9 | pathogenic serotypes may cause bloody diarrhoea, hemolytic uremic syndrome, acute renal failure, and sepsis [39] |
| M. morganii | 1 | 2.9 | infections in immunocompromised patients; nosocomial infections [40] |
| N. resinovorum | 1 | 2.9 | They are found in lake, soil, and water [41]. |
| P. septica | 1 | 2.9 | bacteraemia in immunocompromised patients, those with comorbidities and with vascular catheters [42] |
| P. fungorum | 1 | 2.9 | opportunistic bacterium [43] |
| P. putida | 2 | 5.9 | opportunistic pathogen causing nosocomial infections mainly in neutropenic patients, cancer patients, neonatal patients, and those with cystic fibrosis [44] |
| P. xantuomarina | 1 | 2.9 | no literature data available |
| R. pickettii | 7 | 20.5 | Waterborne opportunistic pathogen [45]. Transmission may occur due to contaminated medical devices or solutions typical of health care facilities (post-dialysis sepsis) [46,47]. The source may be a contaminated, intravascular solution intended for haematological patients [45]. This causes diseases in patients with compromised immunity, respiratory infections—especially in patients with cystic fibrosis, meningitis, peritonitis, and sepsis. |
| S. maltophilia | 7 | 20.5 | It mainly causes nosocomial infections (bacteraemia, biliary tract infections, urinary tract infections, respiratory infections, skin and soft tissue infections, endocarditis) [48,49]. Nosocomial infections, usually in those with comorbidities (e.g., malignancy, HIV) and with chronic lung diseases or lung cancer. This species was classified as an ESKAPE pathogen due to its high level of drug resistance [48]. |
| A. russicus | 1 | 2.9 | no literature data available |
| Gram-positive granulomas | |||
| E. faecalis | 1 | 2.9 | dental root canal infections [50]; aetiologic agent of endocarditis; bacteraemia in patients with comorbidities [51] |
| M. luteus | 8 | 25.53 | opportunistic pathogen that causes infections such as endocarditis or bacteraemia in cancer patients [52] |
| P. polychromogenes | 2 | 5.9 | no literature data available |
| P. oxydans | 1 | 2.9 | no literature data available |
| S. cohnii | 3 | 8.8 | catherer-related infections, meningitis, urinary tract infections, and cholecystitis [53,54]; valve endocarditis in immunocompetent patients [55] |
| S. haemolyticus | 10 | 29.41 | opportunistic nosocomial pathogen—bacteraemia, meningitis, skin infections, prosthetic joint infections, and endocarditis [56] |
| S. capitis | 7 | 20.5 | opportunistic nosocomial pathogen that causes bloodstream infections, joint and valve prosthesis infections, bacterial endocarditis with subsequent osteomyelitis [57] |
| S. epidermidis | 23 | 67.65 | skin microbiota; an important opportunistic pathogen that causes bloodstream infections, endocarditis, osteomyelitis, and abscesses in immunocompromised patients; these infections are associated with the use of intravascular catheters, valves, prosthetic heart valves, artificial lenses, and orthopaedic implants [58]. |
| S. hominis | 5 | 14.7 | potentially opportunistic and nosocomial pathogen that causes infections in patients with compromised immune systems (infective endocarditis) [59] |
| S. pasteuri | 5 | 14.7 | opportunistic pathogen in immunocompromised patients—bacteraemia in patients with leukemia [60]; urinary tract infection associated with the use of a urinary catheter in a patient receiving chemotherapy; endocarditis [61]; osteomyelitis [62] |
| S. warneri | 20 | 58.82 | infections in immunocompromised patients (endocarditis, sepsis, septic arthritis, meningitis, cutaneous botryomycosis) [63]; however, there are cases of endocarditis in an immunocompetent patient (early and late endocarditis) after tooth extraction or mammoplasty [64]. |
| S. aureus | 5 | 14.7 | causes pneumonia, endocarditis, osteomyelitis, and sepsis in hospitalised and immunocompromised patients [58] |
| S. xylosus | 2 | 5.9 | Late knee joint infection in a patient who underwent total knee alloplasty 18 years earlier; commensal bacterium associated with skin and mucous membranes, rarely involved in infections [65] |
| S. succinus | 1 | 2.9 | no literature data available |
| S. parasanquinis | 1 | 2.9 | It causes endocarditis. It causes infections in 10% of oncological patients; peritonitis was found [66]. |
| S. sanguinis | 2 | 5.9 | subacute infective endocarditis; septic arthritis; in patients with periodontal disease, endocarditis, or valvular heart disease [58] |
| S. oralis | 2 | 5.9 | low pathogenicity; in rare cases it may cause meningitis in patients after dental procedures and with poor oral hygiene [24]; rare cases of peritonitis associated with peritoneal dialysis [67] |
| S. salivarius | 1 | 2.9 | exogenous and endogenous intraocular inflammation in patients with comorbidities [68] |
| Gram-positive bacilli (red, spore-forming) | |||
| B. pumilus | 6 | 17.6 | septic arthritis in healthy individuals [69] and skin infections [70]; sepsis in a newborn was described in the literature [71]. |
| B. mycoides | 3 | 8.8 | blood poisoning described in the literature [72] |
| B. weihenstephanensis | 3 | 8.8 | non-pathogenic, dairy contamination [73] |
| B. cereus | 3 | 8.8 | Bacteraemia in immunocompromised patients and haematological malignancies [71] |
| B. simplex | 4 | 11.76 | no literature data available |
| B. muralis | 3 | 8.8 | no literature data available |
| B. megaterium | 2 | 5.9 | considered non-pathogenic or at least of very low malignity [74]; however, it may cause pleurisy, inflammation of the eye, dermatitis, and brain abscesses. |
| C. novyi | 1 | 2.9 | aetiological agent of severe soft tissue infections in injection heroin users; bacteraemia and hepatic gas gangrene in a patient with gastric cancer and diabetes [75,76] |
| L. boronitolerans | 1 | 2.9 | no literature data available |
| L. coleohominis | 1 | 2.9 | considered non-pathogenic; isolated from urine and cervix without clinical description [77] |
| L. paracasei | 1 | 2.9 | caries, sepsis, pneumonia, infective endocarditis, or splenic abscesses in immunocompromised patients [78] |
| Paenibacillus spp. (Gram-positive or Gram-variable) | 1 | 2.9 | no literature data available |
| Gram-negative bacilli | |||
| B. aurantiaca | 2 | 5.9 | Usually nosocomial infections. The role of this microorganism in human pathogenicity needs further studies but it was linked to two cases of bloodstream infection [79]. |
| B. diminuta | 3 | 8.8 | nosocomial infections; peritonitis in a patient with end-stage renal failure; lower leg ulceration in a patient with glomerulonephritis; keratitis; pleurisy; bacteraemia in diabetic and haematological patients [79] |
| Brevundimonas spp. | 1 | 2.9 | nosocomial infections [79]. |
| S. paucimobilis | 1 | 2.9 | nosocomial (hospital-acquired) and community-acquired infections in patients with chronic diseases and immunosuppressed patients; sepsis, septic pulmonary embolism, septic arthritis, and intraocular inflammation [14,80], wound infections [8,20], septic shock in a patient with burns [4], catheter-related bacteraemia [19], pneumonia [19], splenic abscesses [31], urinary tract infection, empyema [10], peritonitis [5,8,12,19,30]. There were also cases of invasive infections such as meningitis, osteomyelitis [33]. It was reported that S. paucimobilis was isolated from maxillary sinus washouts in four patients, as the irrigation solution (saline) was contaminated with this microorganism [81]. |
| Fungi and mould | |||
| C. parapsilosis | 2 | 5.9 | opportunistic pathogen, superficial and systemic candidiasis in oncological patients [82] |
| Rhodotorula spp. | 1 | 2.9 | fungemia in patients with impaired immune system function; catheter-related sepsis [82]; endocarditis, meningitis [83] |
| Alternaria spp. | 17 | 50 | sinusitis, skin infections in immunosuppressed patients [82] |
| A. niger | 3 | 8.8 | ear infection, pulmonary aspergillosis in immunocompromised patients [81,82], sinusitis [84] |
| Cladosporium spp. | 9 | 26.47 | rarely pathogenic [80] |
| Fusarium spp. | 2 | 5.9 | sinusitis in patients with leukemia [82,84], keratitis, pneumonia, hematogenous spread [84] |
| F. oxysporum | 13 | 38.2 | isolated from the blood of a patient with leukemia and invasive fusariosis [82] |
| Penicilum spp. | 4 | 11.76 | keratitis, pneumonia, endocarditis [85] |
| Other | |||
| A. Toluolicum | 1 | 2.9 | no literature data available |
| Category | Unit | Bottle under the Dental Chair | Cup CFU/mL | Water Container in the Room |
|---|---|---|---|---|
| Surgical | 1 | S. cohnii 2.7 × 103 C. novyi 3.8 × 103 | S. warneri 8.5 × 103 | |
| 1 | ||||
| 2 | M. luteus 7 × 103 S. pasteuri 1.35 × 104 | |||
| 4 | S. pasteuri 3.4 × 103 S. warneri 2.7 × 103 | |||
| 6 | Rhodotorula spp. 1.99 × 104 | |||
| 7 | R. pickettii 1.4 × 103 | |||
| 8 | B. mycoides 1.1 × 103 L. shinshuensis 4.2 × 103 C. metallidurans 6.4 × 103 | |||
| Conservative | 1 | C. metallidurans 1.3 × 103 B. cepacia 6 × 102 | R. pickettii 4.3 × 104 S. epidermidis 1.2 × 103 | |
| 1 | ||||
| 2 | B. cepacia 1.3 × 103 | B. simplex 1.2 × 103 S. aureus 4.6 × 102 | ||
| 2 | S. epidermidis 7.1 × 103 | |||
| 1 | ||||
| 2 | S. epidermidis 1.02 × 104 B. pumilus 2.08 × 104 | |||
| 3 | M. luteus 2.6 × 104 | |||
| 4 | R. picketti 1.0 × 103 | S. epidermidis 1.14 × 104 | ||
| 3 | S. epidermidis 6.1 × 103 | |||
| 1 | ||||
| 2 | M. luteus 2.2 × 103 | B. pumilus 3.00 × 104 | ||
| 4 | R. picketti 3.3 × 103 S. warneri 1.6 × 103 S. haemolyticus 1.6 × 103 C. metallidurans 1.9 × 103 | R. amarae 7.6 × 103 | ||
| 5 | M. luteus 1.2 × 103 B. cepacia 1.4 × 103 | |||
| 4 | B. pumilus 2.13 × 104 M. luteus 8.8 × 103 | R. picketti 4.7 × 103 S. aureus 1.09 × 103 | ||
| 1 | ||||
| 2 | C. pauculus 3.8 × 104 | M. luteus 2.1 × 103 C. pauculus 1.4 × 104 | ||
| 3 | S. epidermidis 2.2 × 103 S. capitis 9.2 × 103 B. diminuta 4.7 × 103 | |||
| 4 | R. pickettii 6.46 × 104 R. amarae 5.01 × 102 S. epidermidis 3.5 × 103 | S. pasteuri 1.12 × 104 A. citratiphilum 6.46 × 104 B. pumilus 7.6 × 103 | ||
| Periodontal | 1 | B. simplex 6 × 102 | S. epidermidis 1.2 × 104 R. pickettii 2.9 × 103 | |
| 2 | ||||
| 2 | S. epidermidis 2.9 × 104 S. pasteuri 1.64 × 104 | R. pickettii 5.4 × 103 S. epidermidis 2.34 × 103 | ||
| 4 |
Publisher’s Note: MDPI stays neutral with regard to jurisdictional claims in published maps and institutional affiliations. |
© 2022 by the authors. Licensee MDPI, Basel, Switzerland. This article is an open access article distributed under the terms and conditions of the Creative Commons Attribution (CC BY) license (https://creativecommons.org/licenses/by/4.0/).
Share and Cite
Błaszczyk, B.; Pajączkowska, M.; Nowicka, J.; Szymonowicz, M.; Zakrzewski, W.; Lubojański, A.; Hercuń-Jaskółka, M.; Synowiec, A.; Fedorowicz, S.; Dobrzyński, W.; et al. Microbiological Evaluation of Water Used in Dental Units. Water 2022, 14, 915. https://doi.org/10.3390/w14060915
Błaszczyk B, Pajączkowska M, Nowicka J, Szymonowicz M, Zakrzewski W, Lubojański A, Hercuń-Jaskółka M, Synowiec A, Fedorowicz S, Dobrzyński W, et al. Microbiological Evaluation of Water Used in Dental Units. Water. 2022; 14(6):915. https://doi.org/10.3390/w14060915
Chicago/Turabian StyleBłaszczyk, Bartłomiej, Magdalena Pajączkowska, Joanna Nowicka, Maria Szymonowicz, Wojciech Zakrzewski, Adam Lubojański, Marlena Hercuń-Jaskółka, Aleksandra Synowiec, Sebastian Fedorowicz, Wojciech Dobrzyński, and et al. 2022. "Microbiological Evaluation of Water Used in Dental Units" Water 14, no. 6: 915. https://doi.org/10.3390/w14060915
APA StyleBłaszczyk, B., Pajączkowska, M., Nowicka, J., Szymonowicz, M., Zakrzewski, W., Lubojański, A., Hercuń-Jaskółka, M., Synowiec, A., Fedorowicz, S., Dobrzyński, W., Rybak, Z., & Dobrzyński, M. (2022). Microbiological Evaluation of Water Used in Dental Units. Water, 14(6), 915. https://doi.org/10.3390/w14060915

